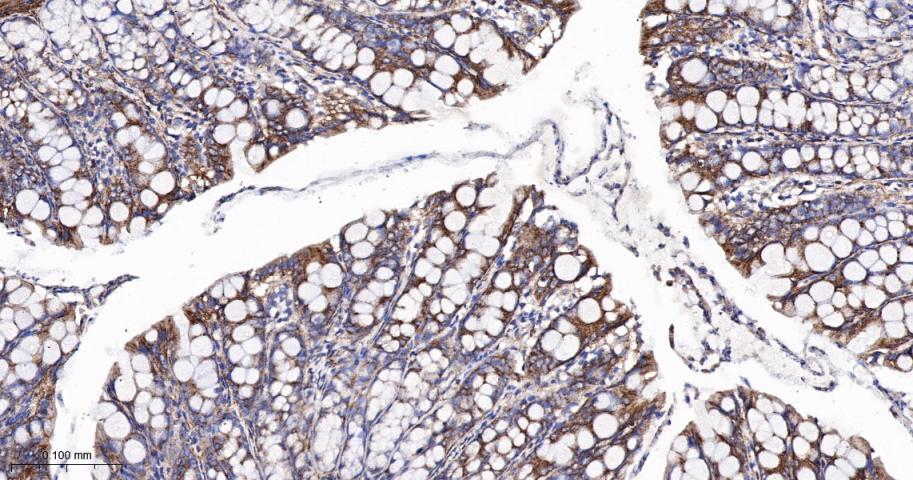
肾上腺素能受体β2重组兔单抗

肾上腺素能受体β2重组兔单抗
Rrmab?兔单抗

货号:bsm-52880R
产品详情
相关标记
相关产品
相关文献
常见问题
概述
产品编号
bsm-52880R
产品类型
重组兔单抗
英文名称
ADRB2 Recombinant Rabbit mAb
中文名称
肾上腺素能受体β2重组兔单抗
英文别名
ADRB2R; ADRBR; ARB2; B2AR; BAR; BETA2AR; Adrb-2; Badm; Gpcr7; ADRB2_HUMAN; ADRB2; Beta-2 adrenoreceptor (Beta-2 adrenoceptor); ADRB2_MOUSE; ADRB2_RAT;
抗体来源
Rabbit
免疫原
A synthesized peptide derived from human beta 2 Adrenergic receptor: 360-413/413
亚型
IgG
性状
Liquid
纯化方法
affinity purified by Protein A
克隆类型
Recombinant
克隆号
7C1
理论分子量
60 kDa
浓度
1mg/ml
储存液
0.01M TBS (pH7.4) with 1% BSA, 0.02% Proclin300 and 50% Glycerol.
研究领域
SWISS
Gene ID
保存条件
Shipped at 4℃. Store at -20℃ for one year. Avoid repeated freeze/thaw cycles.
注意事项
This product as supplied is intended for research use only, not for use in human, therapeutic or diagnostic applications.
数据库链接
背景资料
Beta 2 Adrenergic Receptor is a member of the G protein coupled receptor superfamily. This receptor is directly associated with one of its ultimate effectors, the class C L type calcium channel Ca(V)1.2. This receptor channel complex also contains a G protein, an adenylyl cyclase, cAMP dependent kinase, and the counterbalancing phosphatase, PP2A. The assembly of the signaling complex provides a mechanism that ensures specific and rapid signaling by this G protein coupled receptor. This gene contains no introns in either its coding or untranslated sequences. Different polymorphic forms, point mutations, and/or downregulation of this gene are associated with nocturnal asthma, obesity and type 2 diabetes. Expression of the beta 2 Adrenergic Receptor has been reported in adipose, blood, brain, heart, lung, nose, pancreas, skeletal muscle, skin, and vessel.

产品应用
| 应用 | 已检合格种属 | 预测种属 | 推荐稀释比例 |
|---|---|---|---|
| IHC-P | Human, Mouse, Rat | 1:100-500 | |
| IHC-F | Human, Mouse, Rat | 1:100-500 | |
| IF | Human, Mouse, Rat | 1:100-500 |
交叉反应
交叉反应: Human, Mouse, Rat
相关产品
暂无相关产品
靶标
基因名
ADRB2
蛋白名
beta-2 adrenergic receptor
亚基
Binds SLC9A3R1 and GPRASP1. Interacts with ARRB1 and ARRB2. Interacts with SRC, USP20 and USP33. Interacts with VHL; the interaction, which is increased on hydroxylation of ADRB2, ubiquitinates ADRB2 leading to its degradation. Interacts with EGLN3; the interaction hydroxylates ADRB2 facilitating VHL-E3 ligase-mediated ubiquitination.
亚细胞定位
Cell membrane; Multi-pass membrane protein. Note=Colocalizes with VHL at the cell membrane.
翻译后修饰
Palmitoylated; may reduce accessibility of Ser-345 and Ser-346 by anchoring Cys-341 to the plasma membrane. Agonist stimulation promotes depalmitoylation and further allows Ser-345 and Ser-346 phosphorylation.
Phosphorylated by PKA and BARK upon agonist stimulation, which mediates homologous desensitization of the receptor. PKA-mediated phosphorylation seems to facilitate phosphorylation by BARK.
Phosphorylation of Tyr-141 is induced by insulin and leads to supersensitization of the receptor.
Polyubiquitinated. Agonist-induced ubiquitination leads to sort internalized receptors to the lysosomes for degradation. Deubiquitination by USP20 and USP33, leads to ADRB2 recycling and resensitization after prolonged agonist stimulation. USP20 and USP33 are constitutively associated and are dissociated immediately after agonist stimulation. Ubiquitination by the VHL-E3 ligase complex is oxygen-dependent.
Hydroxylation by EGLN3 occurs only under normoxia and increases the interaction with VHL and the subsequent ubiquitination and degradation of ADRB2.
Phosphorylated by PKA and BARK upon agonist stimulation, which mediates homologous desensitization of the receptor. PKA-mediated phosphorylation seems to facilitate phosphorylation by BARK.
Phosphorylation of Tyr-141 is induced by insulin and leads to supersensitization of the receptor.
Polyubiquitinated. Agonist-induced ubiquitination leads to sort internalized receptors to the lysosomes for degradation. Deubiquitination by USP20 and USP33, leads to ADRB2 recycling and resensitization after prolonged agonist stimulation. USP20 and USP33 are constitutively associated and are dissociated immediately after agonist stimulation. Ubiquitination by the VHL-E3 ligase complex is oxygen-dependent.
Hydroxylation by EGLN3 occurs only under normoxia and increases the interaction with VHL and the subsequent ubiquitination and degradation of ADRB2.
相似性
Belongs to the G-protein coupled receptor 1 family.
Adrenergic receptor subfamily. ADRB2 sub-subfamily.
Adrenergic receptor subfamily. ADRB2 sub-subfamily.
功能
Beta-adrenergic receptors mediate the catecholamine-induced activation of adenylate cyclase through the action of G proteins. The beta-2-adrenergic receptor binds epinephrine with an approximately 30-fold greater affinity than it does norepinephrine.
标记抗体
暂无标记数据
同靶标产品
暂无同靶标产品
相关文献
提示: 发表研究结果有使用 bsm-52880R 时请让我们知道,以便我们可以引用参考文章。作为回馈,资料提供者将获得我们送上的小礼品。
暂无相关文献
常见问题
暂无常见问题